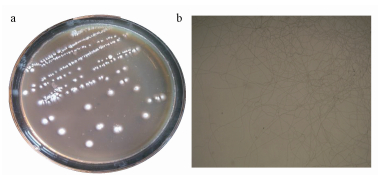

1 引言(Introduction)
印染廢水的處理一直是污水處理行業的難題, 而微生物處理法是比較有應用前景, 且不會產生二次污染的處理方法, 它能夠將染料分子降解成無色或轉化成低毒、無毒的化合物, 也是國內外相關領域一直研究的熱點, 但目前的相關研究主要集中在偶氮類、雜環類、蒽醌類廢水方面, 對于三芳基甲烷類廢水的處理研究相對較少且不夠深入.苯胺藍是一種典型的三芳基甲烷類染料, 結構復雜, 并廣泛應用于生物染色、紡織品行業, 苯胺藍在自然狀態下很難被降解或轉化, 因此, 產生的廢水對環境造成了嚴重的污染.以往對苯胺藍脫色的研究主要以真菌(白腐真菌)為主, 然而, 利用真菌脫色染料廢水存在一定的缺陷:①多數真菌生長和代謝的周期長, C源利用的多樣性較差;②多數真菌是依靠產酶對染料分子進行降解, 但真菌產酶條件苛刻, 受到C、N源的限制性調控較強;③真菌酶的穩定性是限制其大規模應用的主要原因.基于此, 本文以水溶性苯胺藍作為典型污染物模型, 篩選能夠利用多底物的耐熱苯胺藍降解放線菌, 并進行鑒定和污染物的降解研究, 以期為放線菌在三芳基甲烷污水處理中的應用奠定基礎.
2 實驗材料與方法(Materials and methods) 2.1 實驗材料 2.1.1 土壤樣品
主要采集地:陜西省西安市長安區境內秦嶺山麓.采集方法:除去地面植被, 按蛇形法采集底層腐殖質土壤, 然后混合, 4 ℃保存.
2.1.2 培養基、菌種
高氏1號培養基:參照文獻.苯胺藍脫色平板:葡萄糖20.0 g, KNO3 1.0 g, MgSO4 0.5 g, K2HPO4 0.5 g, 瓊脂15.0 g, 苯胺藍0.1 g, 蒸餾水1000 mL, pH自然.苯胺藍液體脫色培養基:葡萄糖20.0 g, KNO3 1.0 g, MgSO4 0.5 g, K2HPO4 0.5 g, 苯胺藍0.1 g, 蒸餾水1000 mL, pH自然.菌種:灰色鏈霉菌標準菌株JF (陜西省微生物研究所保藏中心)
2.1.3 主要儀器與試劑
恒溫培養箱、恒溫搖床、PCR儀、電泳儀、全波長掃描儀、微生物自動分析儀(Biolog)、脫色搖床、冷凍離心機等;苯胺藍(水溶性)、DNA提取試劑盒.
2.2 實驗方法 2.2.1 菌株篩選
稱1 g土壤倒入10 mL無菌水中, 搖勻, 并于65 ℃保溫1 h, 冷卻后依次稀釋至10-2、10-3、10-4、10-5、10-6、10-7;然后用移液器吸取100 μL打入苯胺藍脫色平板中, 涂布均勻, 30 ℃倒置避光靜止培養, 每隔12 h觀察平板的脫色情況, 并從中挑取具有脫色圈的放線菌, 接入高氏1號培養基上.
2.2.2 菌株C源利用特性及遺傳鑒定
利用插片法將菌株在平板上培養至長出孢子, 然后將蓋玻片放在載玻片上, 在顯微鏡下觀察菌株的菌絲形態;同時, 用無菌棉簽從培養皿中蘸取表面孢子(注意不要接觸到培養基), 在IF-A比濁管中分散至濁度達到90%~98%之間, 然后用8排自動移液器將菌液加入Biolog genⅢ96孔板中, 30 ℃靜置培養, 每隔24 h用Biolog微生物自動分析儀測定對C源及生物因子的利用情況.
用DNA提取試劑盒對高氏1號液體培養的菌株進行DNA提取, 采用通用引物進行擴增, 電泳驗證, PCR產物在蘇州金唯智公司測序, 然后序列在NCBI中進行Blast比對, 構建進化樹.
2.2.3 菌株液體苯胺藍脫色實驗
配制質量分數0.05‰的苯胺藍標準溶液, 在可見-紫外全波長掃描儀上進行全波段掃描, 確定苯胺藍的特征吸收位點.
將初篩得到的菌株接入液體苯胺藍脫色試管中, 分別在30 ℃下進行搖床培養, 每隔12 h記錄脫色情況, 并進行苯胺藍各基團脫除率的測定.收集菌體, 加入無菌水進行搖瓶解析48 h, 10000 r·min-1離心, 取上清液測定菌體對苯胺藍的吸附作用.
3 結果與分析(Result and analysis) 3.1 苯胺藍脫色平板初篩
利用苯胺藍脫色平板初步獲得1株放線菌AG-56, 單獨點接到苯胺藍平板和液體苯胺藍中驗證其脫色能力, 結果如圖 1所示.從圖 1中可以看出, 所篩選的放線菌菌株AG-56在苯胺藍平板上培養48 h, 產生明顯的透明圈, 且透明圈的大小明顯大于菌落生長的大小, 說明此菌株能夠產生使苯胺藍褪色的生物酶.而根據文獻(Archibald et al., 1992), 該生物酶可能是氧化酶類, 并且是屬于胞外酶.從液體脫色情況來看, 接入菌株AG-56的培養基中苯胺藍的顏色基本消失, 而對照組苯胺藍的顏色無變化, 說明菌株AG-56對苯胺藍具有很強的脫色能力, 且通過對離心后的沉淀分析可知, 菌株對苯胺藍的脫色不僅僅依靠胞外酶, 還有可能菌體自身對苯胺藍具有一定的直接吸附作用(Si et al., 2013).

圖 1 菌株AG-56對苯胺藍的脫色作用(a.苯胺藍平板, b.苯胺藍液體培養3 d后離心上清液)
3.2 菌株生理生化特性及遺傳鑒定 3.2.1 菌株形態
從圖 2可知, 菌株AG-56無論在菌落形態還是顯微形態都具有明顯的放線菌特征.但此菌株在高氏平板上的氣生菌絲并不發達, 孢子成熟后變成灰色(圖 2a);顯微鏡下AG-56菌絲細長, 相互纏繞, 氣生菌絲無分支, 無隔膜(圖 2b).
圖 2 AG-56培養平板(a, 3 d)與顯微的(b, 400倍)形態
3.2.2 Biolog平板C源利用實驗
Biolog平板C源平板是考察目標菌株對71種C源和23種因子的敏感程度的方法(Garland et al., 1991).對AG-56與灰色鏈霉菌JF (Streptomyces griseochromogenes)進行了71種C源和23種敏感因子測試對比.從圖 3可以看出, 在培養初期, 菌株AG-56對C源的利用多樣性要低于對比菌株, 且兩者對C源的選擇性利用表現出了比較大的差異性.菌株AG-56在培養初期能夠利用A4(海藻糖)、A5(纖維二糖)、A6(龍膽二糖)、A7(蔗糖)、B1(棉籽糖)、C1(葡萄糖)等15種C源.通過在590 nm和750 nm處吸光值對比發現, 15種C源中對C1(葡萄糖)的利用率最高, 說明葡萄糖是菌株AG-56的最直接C源;而對比菌株(Streptomyces griseochromogenes)在初期能夠利用21種C源, 但只有A5(纖維二糖)、C1(葡萄糖)、H1(吐溫40)、H4(β-羥基-D, L丁酸)、H6(乙酰乙酸)、H8(乙酸)6種C源與菌株AG-56相同, 說明兩者的直接C源特性相差較大.

圖 3 AG-56(a.24 h, b.120 h)與對比菌株(c.24 h, d.120 h) C源、敏感因子代謝圖(黑色實心圓表示對該因子/碳源非常敏感/可利用-陽性;灰白色半圓表示對該因子/碳源較為遲鈍/可利用性差-半陽性;白色圓圈表示對該因子/碳源非常遲鈍/不可利用-陰性)
隨著培養的進行, 經過不同C源的連續誘導, 菌株AG-56的C源利用開始呈現多樣性, 在培養120 h后除B2(乳糖)、B6(N-乙酰-D-葡糖胺)、D2(甘露醇)外, 其它碳源都有所利用;而對比菌株經過120 h后, 可利用C源數量稍有增加, 但多樣性顯著低于AG-56.說明菌株AG-56具有很強的適應能力, 且在復雜C源的條件下依然能夠生長旺盛, 在成分復雜的污水處理方面展現出了一定的應用前景.
在敏感因子方面, 菌株AG-56在培養初期對大多數因子比較敏感, 隨著培養的進行, 菌株慢慢對抑制因子產生了一定的抗性, 在培養120 h時, 菌株對D11(利福霉素)、H10(氨曲南)、G10(萘啶酮酸)、G12(亞碲酸鉀)、高鹽及低pH產生了耐性.對比菌株Streptomyces griseochromogenes在培養初期對敏感因子的抗性要稍強于測試菌株AG-56, 但培養120 h后, 對比菌株雖然抗性因子的種類有所增加, 但稍差于測試菌株, 主要表現在G10(耐鼎酮酸)、G11(氯化鋰)、G12(亞碲酸鉀)、H10(氨曲南)的抗性上.菌株AG-56在復雜環境中表現出了很強的適應能力和代謝多樣性, 具有極高的潛在利用價值.
3.2.3 遺傳學鑒定
通過16S rDNA測序得到1485個堿基, 并與NCBI數據庫中比對, 發現菌株AG-56與放線菌中鏈霉菌屬的序列相似性達到99%, 并與灰色鏈霉菌(Streptomyces griseochromogenes)屬同一分支.利用MAGA4軟件構建系統發育樹, 結果如圖 4所示.

圖 4 AG-56遺傳進化樹
3.3 液體苯胺藍脫色試驗
對苯胺藍標品做全波長掃描結果(圖 5)顯示, 液體苯胺藍在192、314、602 nm處具有明顯的吸收峰, 602 nm處是苯胺藍發色基團的吸收峰, 這與文獻(張瑞景, 2014)報道一致, 192、314 nm處是紫外基團的吸收峰, 文獻中未見報道, 且以往的研究主要針對可見區基團的降解, 并未涉及紫外吸收基團的降解.

圖 5 苯胺藍標品全波長掃描(圖中1、2、3表示對應的出峰順序)
鏈霉菌AG-56對苯胺藍3個特征波長基團的降解率如圖 6所示.從圖 6中菌株生長曲線與降解曲線的關系可以看出, 菌株對苯胺藍的降解主要發生在菌種進入穩定期后.即60 h前主要是菌種的生長及誘導產酶期, 并伴隨菌株對苯胺藍的吸附作用(圖 7), 這與真菌對染料的降解相似(Si et al., 2013).對于602、314 nm處基團, 菌體吸附發揮作用主要在前期, 60 h以后, 菌體吸附的貢獻率直線下降;且從理論上講, 菌體對苯胺藍的吸附是有限的, 而后期主要依靠菌體產酶對苯胺藍的降解, 602 nm處基團降解96 h, 降解率達到70%以上, 菌株對602 nm處基團的降解是苯胺藍脫色的主要原因.對314 nm處基團的降解主要發生在72 h后, 并且在監測時間內, 最大降解率只達到了32%, 而菌體吸附作用也只提供了10%以下的去除率.對苯胺藍192 nm處基團的降解自菌體生長開始就處于一種穩步上升的趨勢, 說明菌體對此波長處基團的吸附作用最大, 雖然72 h后, 降解效率稍有提高, 但從圖 7中可以明顯看出, 菌體的吸附作用仍然占有80%以上的去除貢獻率.當最大降解率達到48%時, 菌體吸附仍然是192 nm處基團去除的主要作用.

圖 6 菌株AG-56對苯胺藍的脫除曲線

圖 7 AG-56菌體吸附作用對苯胺藍脫除的貢獻率
因此, 菌株對苯胺藍特征基團的降解能力順序為602 nm基團>192 nm基團>314 nm基團, 并由圖可推測AG-56對602 nm、314 nm處基團的降解主要是依靠菌株進入穩定期后產酶的作用, 對192 nm處基團的脫除存在物理吸附和產酶降解兩種主要作用(Si et al., 2013), 且以菌體吸附作用為主.
從圖 8可以看出, 在AG-56對苯胺藍的脫色過程中, pH隨著菌體的生長逐漸降低, 特別是60 h后, 菌體進入穩定期, 苯胺藍進入了快速降解期, pH也下降較快.這說明菌體進入穩定期后, 可能開始分泌能夠降解苯胺藍的酸性酶類, 隨著酶分泌的越多, 使得pH呈現下降趨勢.

圖 8 苯胺藍降解過程中pH的變化
4 討論(Discussion)
微生物法是降解苯胺藍等復雜染料的有效途徑, 目前對于放線菌用于染料脫色的研究還相對較少, 不過研究發現, 一些放線菌包括分枝桿菌也能夠對三苯基甲烷類染料進行脫色.1991年, 首先報道了放線菌對三苯基甲烷染料的生物降解, 發現兩株放線菌Nocardia corallina和N. globerula對結晶紫具有脫色活性.也發現了5種分枝桿菌(Mycobacterium avium、M. intracellulare、M. scrofulaceum、M. marinum和M.chelonae)均能對孔雀綠和結晶紫進行脫色.國內廣東農科院研究人員篩選到兩株木質素降解鏈霉菌, 在苯胺藍固體平板上培養5 d后, 能產生脫色圈.
本實驗所篩選的放線菌StreptomycesAG-56在多種C源的利用性、可誘導性及對苯胺藍的降解方面都展現了極好的性能, 表明其在污水處理特別是三芳基甲烷類染料廢水處理方面具有較高的應用價值.而后續對于StreptomycesAG-56的研究應主要集中在StreptomycesAG-56的降解機理、分子機制、污染物耐受機制、降解動力學等系統性的科學問題上, 以期能夠為該菌株的工業化應用奠定堅實的理論基礎.
5 結論(Conclusions)
1) 從土壤中分離獲得了一株能夠降解水溶性苯胺藍的放線菌, 經過形態觀察和16S rDNA遺傳鑒定為鏈霉菌屬(Streptomyces), 命名為Streptomyces AG-56, 且通過與鏈霉菌屬中的灰色鏈霉菌對比發現, Streptomyces AG-56菌株具有比灰色鏈霉菌更廣泛的C源利用特性和可誘導性.具體參見污水寶商城資料或http://www.dongaorq.cn更多相關技術文檔。
2) Streptomyces AG-56在液體條件下對苯胺藍的3個吸收波長基團都具有降解能力, 對602 nm處發色基團的降解能力最大, 即能夠對苯胺藍進行脫色.菌種進入穩定期后, pH逐漸下降, 菌體開始分泌降解苯胺藍的酸性酶類, 苯胺藍的降解主要發生在此時期內.另外, 菌株的物理吸附對液體中的苯胺藍具有一定的脫除作用.
致謝(Acknowledgement): 感謝陜西省微生物研究所和西北農林科技大學資源環境學院為本研究所提供的實驗平臺.


